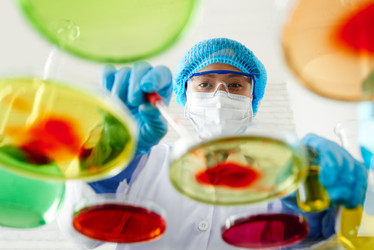
Similar image 12994288

arrow_drop_down

Описание
Девушка с химическими колбами
Автор
ID файла
384182
Формат файла
JPG
Максимальный размер
3008 x 2000 px, 300 dpi
ИзолированныйЖенщиныОборудованиеЖенский ПолНаукаОткрытиеОбразованиеПрофессияКомпетентностьТехнологияОбучениеСтудентУчитьсяТехникБезопасностьНаучно-Исследовательская РаботаЖидкоcтьЭкзаменЛекарствоВрачБольницаСредний Медицинский ПерсоналЛабораторияПерчаткаТрубаКолбаАнализироватьБиохимияБиологияБиотехнологияХимическое ВеществоХимикХимияЛабораторная ТрубкаУчёныйМензуркаОптикаДезоксирибонуклеиновая КислотаМикробиологияБиологЗдравоохранение И МедицинаЗащитные ОчкиПробиркаЕвропейского ПроисхожденияМедицинский АнализНаучный ЭкспериментУрок Химиичеловеклицоевропеецкрупный планженщиназащитныйпрофессиональныйлюдиженщинадевушкапрофессиональныйбелыйкрупный планстеклянныйизучениекрасивыйкрасныйизолированныйпрофессияформаздравоохранениесинийбрюнеткацветноймаскаочкимедицинскийиспытаниелабораториянаучныйэкспериментмедицинскийпластмассовыйбезопасностьхимическийрезиновыйнаукаевропейскийжидкостьмензуркарастворколбазащитныймолодежьопытформенныйперчаткалабораториясоставреспираторхалатклиниканаучный исследованиелаборантка
Ключевые слова
Мы также рекомендуем:
Зарегистрируйтесь, чтобы купить и скачать
это изображение в высоком разрешении.
это изображение в высоком разрешении.
Цены на
стандартную лицензиюarrow_drop_down
для
физлицarrow_drop_down
info_outlineПодписки info_outline
168 ₽240 ₽-30%
за скачивание одного
изображения по подпискеinfo_outline
изображения по подпискеinfo_outline
1,680 ₽ за первый месяц
Далее 2,400 ₽ в месяцinfo_outline
Пакеты изображений info_outline
600 ₽
за скачивание одного изображения штучно
1,200 ₽ за пакет
Зарегистрируйтесь, чтобы купить и скачать
это изображение в высоком разрешении.
это изображение в высоком разрешении.
Уже есть аккаунт? Войти